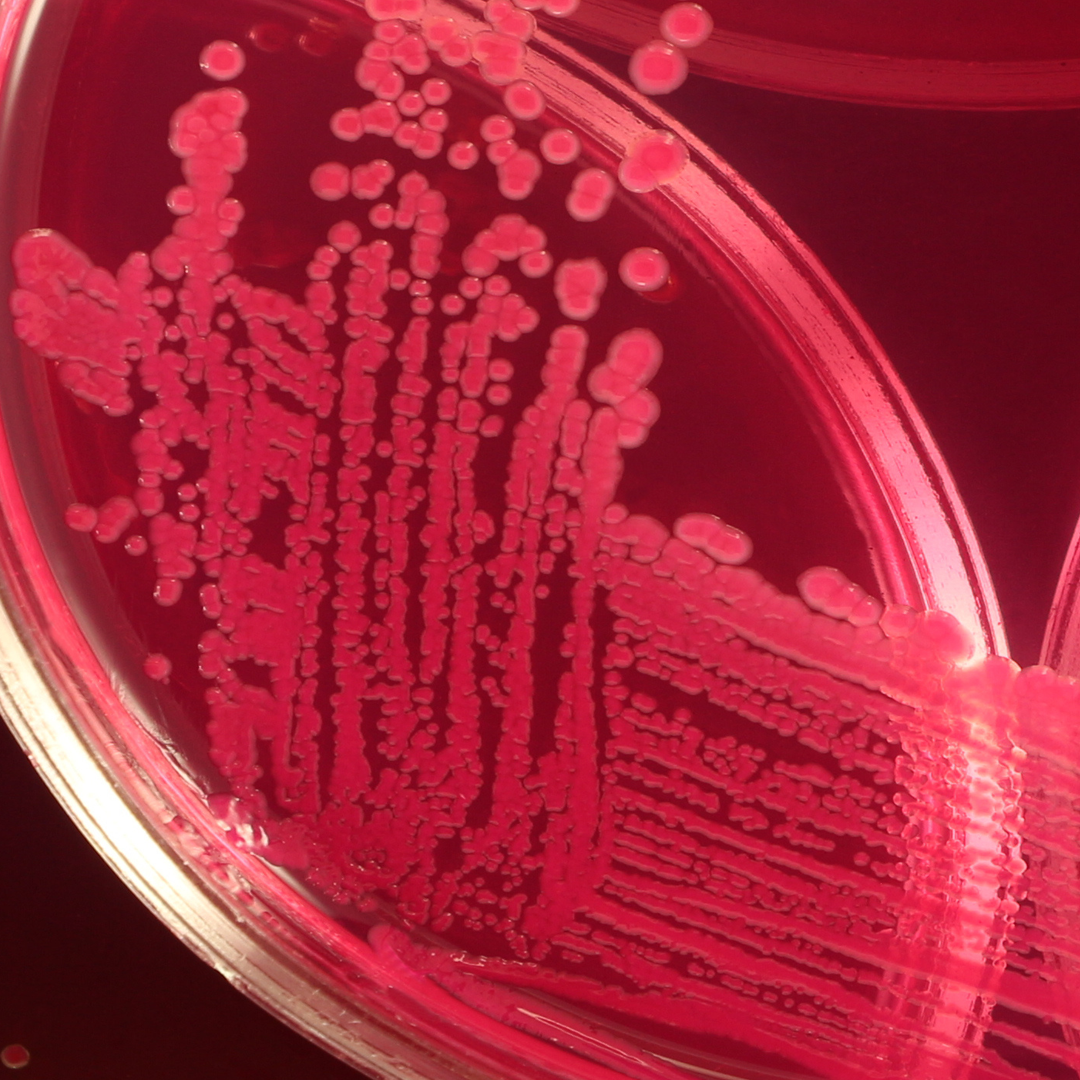
Programa para la Reducción del Uso de Antibióticos

Fytera® Perform
Aceites esenciales que mejoran la tasa de conversión alimenticia
Las soluciones fitogénicas consisten en nuevos ingredientes funcionales de origen vegetal que favorecen los procesos fisiológicos y metabólicos específicos en los animales de producción. Los ingredientes de alta calidad y espectro completo constituyen la base de soluciones muy específicas para los desafíos de la producción avícola.

Beneficios
- Fytera® Perform disminuye la inflamación en el intestino.
- Favorece la adecuada absorción de nutrientes.
- Fortalece la función de la barrera intestinal para evitar la traslocación de patógenos.
Especificaciones
- Fytera® Perform contiene aceites esenciales estandarizados de espectro completo.
- Múltiples componentes bioactivos provenientes de tres aceites esenciales.
- Aplicación: en la premezcla o en el alimento terminado.
Fytera® Perform
-
pdf (1009kB)
Contáctanos
Escríbenos un mensaje y nos pondremos en contacto contigo.